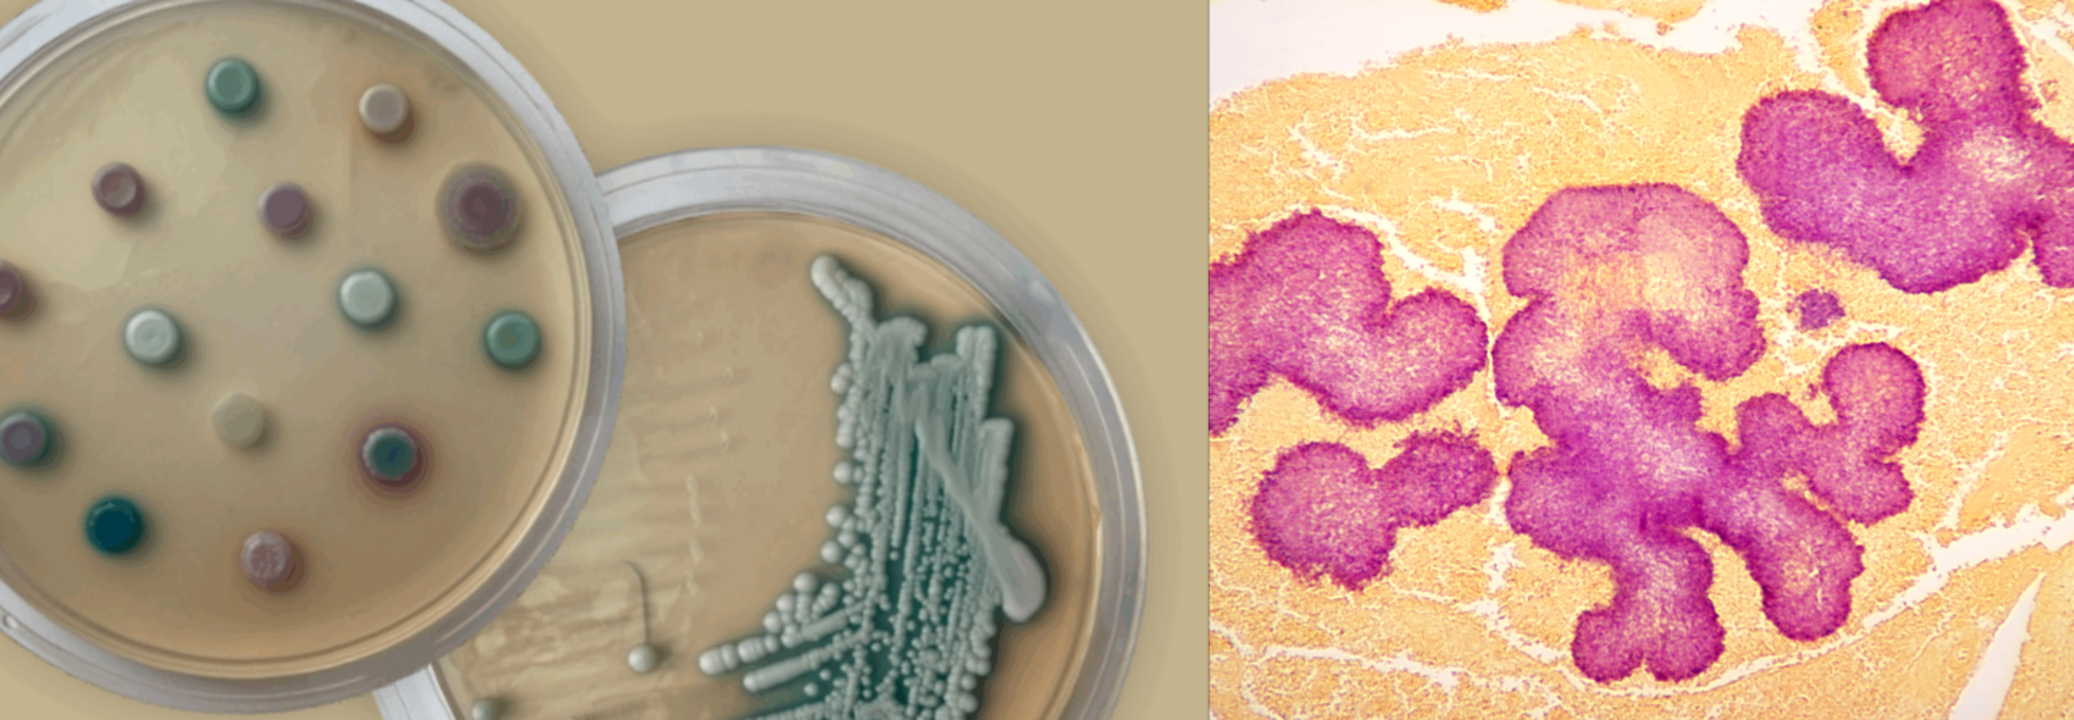

Know All About The Candidozyma Auris, The Fungal Pathogen And A Rising Health Threat
Credits: UKHSA & Canva
SummaryC. auris rarely causes infections in healthy people but can be dangerous for those in hospitals—especially patients who are critically ill, have been admitted for long periods, or have weakened immune systems.
End of Article
